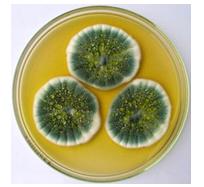

Рекомендуемое время выполнения заданий – 90 минут.
1. (1 балл) Какая из структур клетки содержит зеленый пигмент хлорофилл?
2. (1 балл) К какому виду тканей растений относятся ситовидные трубки?

3. (2 балла) Живые организмы способны определенным образом реагировать на воздействие окружающей среды изменением своего состояния. Как называется такое свойство живых организмов?
4. (3 балла) Какие из растений относятся к споровым растениям? Выберите несколько вариантов ответа.
5. (3 балла) Какие из перечисленных веществ являются органическими? Выберите несколько вариантов ответа.
6. (4 балла) Укажите последовательность появления перечисленных растений в процессе развития растительного мира на нашей планете. Ответ запишите в виде последовательности цифр без пробелов и каких-либо знаков препинания, например, 1234
1. Покрытосеменные
2. Голосеменные
3. Водоросли
4. Папоротники
7. (5 баллов) Соотнесите виды грибов и представителей этих грибов, изображенных на рисунках. Ответ запишите в виде сочетания цифр и букв без пробелов и каких-либо знаков препинания, располагая цифры в порядке возрастания, а буквы, стоящие за ними в алфавитном порядке, например, 1ав2бгде
1. Плесневые грибы
2. Шляпочные грибы
3. Грибы-паразиты
8. (6 баллов) У побережья Британской Колумбии произрастают гигантские бурые водоросли, являющиеся родственниками морской капусты - ламинарии. Такая водоросль за 120 дней достигает длины 54 м. Какой длины (в сантиметрах) была водоросль на 50 день роста. Ответ запишите в виде целого числа без указания единиц измерения, например, 250
9. (7 баллов) Вставьте предложенные слова в текст в правильной последовательности. Ответ запишите в виде ряда цифр без пробелов и каких-либо знаков препинания, например, 1234
1) споровые 5) лист
2) семенные 6) плод
3) липа 7) можжевельник
4) шишка
Голосеменные и покрытосеменные растения являются …растениями, в отличие от папоротников, являющихся … растениями. Как голосеменные, так и покрытосеменные растения имеют корень, стебель и … У голосеменных растений семена располагаются на чешуйках…, а у покрытосеменных – внутри … Покрытосеменными растениями являются яблоня, …, роза, клевер и многие другие растения. Ель, … и сосна, являются голосеменными растениями.
10. (8 баллов) Разгадайте ребусы.
Сколькие из перечисленных грибов являются съедобными? Ответ запишите в виде целого числа, например, 4
Рекомендуемое время выполнения заданий – 90 минут.
1. (1 балл) К какому типу животных относится животное, изображенное на рисунке?

2. (1 балл) Какое из перечисленных простейших имеет жгутик?
3. (2 балла) Из каких частей состоит пестик? Выберите несколько вариантов ответа.
4. (3 балла) Какие клетки преобладают во внутреннем слое тела гидроидных? Выберите несколько вариантов ответа.
5. (3 балла) Известно, что таллом лишайника уснеи густобородой может достигать максимальной длины 30 см. При этом прирост таллома в год не превышает 5 мм. Сколько лет должен прожить лишайник, чтобы достичь максимальной длины. Ответ запишите в виде целого числа без указания единиц измерения, например, 250

6. (4 балла) Соотнесите типы соцветий и растения, имеющие такие соцветия. Ответ запишите в виде сочетания цифр и букв без пробелов и каких-либо знаков препинания, располагая цифры в порядке возрастания, например, 1а2б3в

7. (5 баллов) Дима и Лёша сделали кормушки для птиц, регулярно подкармливали птиц и наблюдали за ними. В первый день к кормушке прилетело 5 больших синиц и 3 самца снегиря обыкновенного. На второй день 4 городских воробья, 4 самки снегиря обыкновенного и 2 большие синицы. На третий – 2 городских воробья, 3 большие синицы и 2 самца снегиря обыкновенного. Сколько видов птиц прилетало к кормушке за эти 3 дня. Ответ запишите в виде целого числа без указания единиц измерения, например, 25
8. (6 баллов) Расставьте в правильной последовательности события, происходящие в цикле развития голосеменных растений, начиная с появления шишек. Ответ запишите в виде последовательности цифр без пробелов и каких-либо знаков препинания, например, 1324
1) происходит созревание пыльцы и формирование семязачатков
2) происходит оплодотворение
3) пыльца разносится ветром
4) образуется зародыш
5) на молодых ветвях появляются шишки
6) семена разносятся ветром
9. (7 баллов) В 1928 году Флеминг изучал свойства бактерий – стафилококков. Александр Флеминг был довольно неряшливый и в его лаборатории зачастую творился бардак. Бактерии стафилококков культивировались в плоских чашках Петри. Однажды, оставив в углу лаборатории все чашки с бактериями, ученый уехал на отдых, а когда вернулся, обнаружил в одной из чашек Петри плесень, которую можно наблюдать на испорченном хлебе. На этой же чашке стафилококки были полностью уничтожены, а в других, не поросших плесенью чашках – бактерии продолжали существовать. Флеминг сделал вывод, что данная плесень вырабатывает некоторое вещество, которое и убивает вредные бактерии. Какая плесень росла в чашке Петри? Ответ запишите одним словом, без каких-либо знаков препинания.
10. (8 баллов) Разгадайте ребусы.

Сколькие из перечисленных растений являются семенными? Ответ запишите в виде целого числа, например, 4
1. (по 1 баллу за каждый пункт) Определите, клетка какой ткани представлена на рисунке.

Выберите, под какой цифрой обозначен отросток клетки – дендрит. В ответ запишите цифру без каких-либо знаков препинания, например, 5
2. (2 балла) Выберите, какую часть ванили душистой используют в кондитерском производстве.

3. (2 балла) Разгадайте филворд и определите названия пяти животных. Среди животных выберите лишнего по признаку терморегуляции организма. Запишите полученное слово в ответе без каких-либо знаков препинания, в именительном падеже и единственном числе.

4. (4 балла) Выберите признаки, которые характерны для женских шишек хвойных растений.

5. (4 балла) Укажите, каким по объему движений является лучезапястный сустав человека.
6. (4 балла) Разгадайте филворд, используя фотографии животных. Из оставшихся букв составьте слово, которое объединяет все эти живые организмы. Запишите полученное слово в ответе без каких-либо знаков препинания.

7. (4 балла) Выберите неправильное утверждение.
8. (4 балла) Разгадайте кроссворд, подсчитайте количество букв «А». В ответе укажите цифру без каких-либо знаков препинания, например, 5
Вопросы к кроссворду:
1. Сосуд, по которому кровь течет от сердца.
2. Бесцветная клетка, имеющая ядро, участвует в уничтожении микробов.
3. Жидкая часть крови, состоящая из воды, органических и минеральных веществ.
4. Тончайший кровеносный сосуд, где происходит обмен между кровью и клетками тканей.
5. Небольшое безъядерное образование, отвечающее за свертывание крови.
6. Безъядерная окрашенная клетка, транспортирующая кислород к тканям и углекислый газ к легким.
7. Особый белок, благодаря которому переносится кислород.

9. (6 баллов) Определите, какой вероятный возраст человека, если на препарате трубчатой кости человека отсутствует эпифизарная пластинка.
10. (6 баллов) Выберите причину следующего явления. При добавлении в культуру инфузории - туфельки капли молока со временем отмечается резкое увеличение их численности.
Рекомендуемое время выполнения заданий – 60 минут.
1. (2 балла) Выберите из живых организмов, представленных на рисунке, гриба-паразита.
2. (2 балла) Выберите, какая трубчатая кость в организме человека самая крупная и мощная.

3. (2 балла) Расположите в правильной последовательности систематические категории, к которым относится большая панда, начиная с наибольшей систематической группы: 1) медвежьи; 2) млекопитающие; 3) хищные; 4) животные; 5) хордовые; 6) большая панда. Ответ запишите в виде комбинации цифр без пробелов и каких-либо знаков препинания, например, 2143

4. (2 балла) Укажите, как называется процесс разрушения природной структуры белков под влияние каких-либо факторов без нарушения первичной структуры. Ответ запишите без каких-либо знаков препинания (одним словом), в именительном падеже и единственном числе.
5. (4 балла) Пройдите лабиринт, соглашаясь или нет с утверждениями, выберите соответствующую букву. В ответе укажите только букву без каких-либо знаков препинания, например, а

6. (4 балла) У морских свинок черный цвет шерсти (В) доминирует над белым (в). При скрещивании двух черных свинок у них родилось два детеныша – черный и белый. Определите генотипы родителей.
7. (4 балла) Укажите стадии митоза, в течение которых хромосомы находятся в спирализованном состоянии.
8. (4 балла) Выберите, какое из положений клеточной теории предложил Р.Вирхов.
9. (4 балла) Укажите путь молекул кислорода и изменения состава крови при газообмене в легких: 1) превращение венозной крови в артериальную; 2) превращение артериальной крови в венозную; 3) кислород в химической связи с гемоглобином; 4) стенка легочного пузырька; 5) стенка капилляра; 6) углекислый газ в плазме крови; 7) воздух в легочном пузырьке. Не все цифры могут быть использованы. Ответ запишите в виде комбинации цифр без пробелов и каких-либо знаков препинания, например, 1432
10. (4 балла) Определите, о каком ученом составлен синквейн. Запишите фамилию ученого в ответе без каких-либо знаков препинания, в именительном падеже и единственном числе.

Рекомендуемое время выполнения заданий – 60 минут.
1. (2 балла) Определите, цикл развития какого организма представлен на рисунке.

2. (2 балла) Выберите, какая наука изучает закономерности взаимодействия организмов между собой и с факторами окружающей среды.
3. (2 балла) Определите способ размножения живых организмов, представленный на рисунке.

4. (4 балла) Выберите правильные утверждения.
5. (4 балла) Укажите стадию жизненного цикла кукушкина льна, обозначенную на рисунке цифрой 2.
6. (4 балла) Установите соответствие между органоидами клетки, изображенными на рисунке, и их характеристиками. Ответ запишите в виде комбинации букв и чисел без пробелов и каких-либо знаков препинания, буквы должны идти в алфавитной последовательности, например, а1б5в3г2

а) Основная часть поверхностного аппарата клетки, которая ограничивает цитоплазму и защищает ее от внешних воздействий, принимает участие в процессах обмена веществ между клеткой и внеклеточной средой
б) Система каналов и полостей, окруженных мембраной, на которых происходит синтез белков, углеводов и липидов
в) Двумембранная структура клетки, которая обеспечивает хранение и реализацию наследственной информации
г) Органоид клетки, который участвует в процессе клеточного дыхания и обеспечивающие клетку энергией в виде АТФ.
7. (4 балла) Установите соответствие между классами рыб и их характерными особенностями.

8. (4 балла) Выберите правильный ответ. Почему молодой картофель при варке рассыпается, яблоки многих сортов при длительном хранении становятся рыхлыми, а перезрелый арбуз лопается?
9. (4 балла) Молекула ДНК состоит из двух цепей – основной, на которой синтезируется иРНК, и комплементарной. Укажите порядок нуклеотидов в синтезируемой иРНК, если порядок следования нуклеотидов в основной (рабочей) цепи ДНК следующий: Ц – Г – Ц – Т – Г – А – Т – А – Г.
10. (6 баллов) В ядрах клеток эндосперма семян злакового растения содержится по 15 пар хромосом. Сколько хромосом будет находиться в ядре яйцеклетки зародышевого мешка у данного растения? Ответ запишите числом, например, 3
Рекомендуемое время выполнения заданий – 60 минут.
1. (2 балла) Выберите, как называются бактерии, имеющие палочковидную форму.

2. (2 балла) Из предложенных на рисунках плодов выберите многосемянной сочный плод.
3. (2 балла) Выберите типы гамет, которые образуются у организма с генотипом ААВb.
4. (4 балла) Выберите, клетки каких из предложенных тканей растений, постоянно делятся.
5. (2 балла) Определите отдел пищеварительной системы по описанию: расширенная часть пищеварительной трубки; расположен между пищеводом и тонким кишечником; мускулатура состоит из продольных, кольцевых и косых мышц; слизистая собрана в складки. Запишите это название в ответе без пробелов, без кавычек и каких-либо знаков препинания.
6. (2 балла) Установите соответствие между видами популяций и их характеристиками. Ответ запишите в виде комбинации цифр и букв без пробелов и каких-либо знаков препинания, цифры должны идти по порядку, например, 1б2а3в4г

7. (4 балла) Выберите последовательность, верно отражающую расположение члеников конечности у насекомых.
8. (4 балла) Установите соответствие между терминами и их определениями. Ответ запишите в виде комбинации цифр и букв без пробелов и каких-либо знаков препинания, цифры должны идти по порядку, например, 1б2а3в4г

9. (4 балла) Определите, о каком ученом составлен синквейн. Запишите только фамилию натуралиста в ответе без каких-либо знаков препинания, в именительном падеже и единственном числе.

10. (4 балла) Выберите, какова причина следующего явления. В XIX веке в Европе после «промышленной революции» резко возросла частота темной формы бабочки березовой пяденицы.